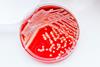
shutterstock_468354608

All Industry Insight articles
-
 News
NewsSandoz partners with Samsung Bioepis to accelerate biosimilar pipeline
New licensing, development and commercialisation agreement could expand Sandoz’s pipeline by to up to 32 assets.
-
 News
NewsUpcycled plastic could facilitate production of Parkinson’s drug
Bioengineered E.coli provide an eco alternative to creating L-DOPA from terephthalic acid, suggests study.
-
 News
NewsEli Lilly doubles down on supply chain investment in Asia
Pharma giant to strengthen manufacturing capabilities in Japan and add capacity in China for its first oral GLP-1 therapy candidate, orforglipron.
-
 News
NewsSana's islet cell transplant therapy shows early promise in type 1 diabetes
Biotech company’s long-term data demonstrated hypoimmune (HIP)-modified islet transplantation without immunosuppression in type 1 diabetes.
-
 News
NewsNeuro-specialist Lundbeck hires new AI lead
New recruit brings over 15 years of leadership experience to the brain health-focused biopharmaceutical company.
-
 News
NewsChiesi and Bespak further collaboration to advance UK production of low carbon inhalers
Partnership increases industrial scale of low carbon pressurised metered dose inhalers (pMDIs), accelerating pharma’s transition to a more sustainable option.
-
 News
NewsGSK grants rare disease firm Alfasigma rights to linerixibat for $690m
Licence agreement with the Italy-based pharma company to advance GSK’s ambitions in rare disease.
-
 News
NewsStudy optimises automated de-bagging in aseptic manufacturing
Mechanical design improvements greatly enhanced success rate during primary de-bagging for double-bag products.
-
 News
NewsFDA revises PK study approach in new biosimilar draft guidance
Sandoz is also adjusting its global strategy by recruiting Armin Metzger as President of Biosimilar Development, Manufacturing & Supply.
-
 News
NewsVinay Prasad to exit CBER as FDA group director
US agency is set to see another new face take the helm, following Dr Prasad’s departure at the end of April.
-
 News
NewsCSL breaks ground on $1.5bn Illinois plasma therapy facility expansion
US manufacturing investment forms part of the firm’s efforts to increase its domestic presence and support its supply network.
-
 News
NewsCleanroom air quality not impaired by height-adjustable furniture
Incorporating ergonomic improvements into pharmaceutical cleanrooms may not negatively impact particle contamination control, according to a new study.
-
 News
NewsServier deepens rare oncology commitment with $2.5bn Day One acquisition
The deal aligns with the biopharma company’s goal of expanding its oncology pipeline by the end of the decade.
-
 News
NewsBiogen/Stoke’s zorevunersen hailed as potential first disease-modifying drug for rare epilepsy
Clinical readout for Dravet syndrome trial part of the collaboration the companies signed in 2025.
-
 News
NewsSanofi gains access to first-in-class JAK inhibitor through $1.5bn licensing deal
Oral small molecule therapy rovadicitnib from Sino Biopharmaceutical offers potential to advance the pharma company’s haematology portfolio.
-
 Article
ArticleThe implementation of biodiversity footprinting – examining supply chains
Carbon accounting is a well recognised means of assessing environmental impact in terms of greenhouse gas emissions, but the ecological effects from business practices are far broader. Dr Tara Garraty reveals how biodiversity footprinting serves to paint a more complete picture.
-
 Report
ReportPharma Horizons: Trends in Pharmaceutical Manufacturing
EPR’s 2026 pharma manufacturing trends report covers the key developments in supply chain, quality, drug development, new modalities and beyond.
-
 News
NewsUCB signs $1.1bn to autoimmune collaboration with Chinese biotech Antengene
License agreement involves development of ATG-201, a B cell-depleting bispecific T-cell engager, supporting the biopharma company’s immunology pipeline.
-
News
NewsNanoparticle–ultrasound combo could boost drug release in bacterial biofilms
Study findings offer potential to improve drug efficacy of hard-to-deliver antibiotics.
-
 News
NewsBlueprint’s rare disease drug Ayvakit shows long-term benefit
D816V-targeted therapy provided robust symptom control in patients with indolent systemic mastocytosis, supporting its use as a long-term treatment.



